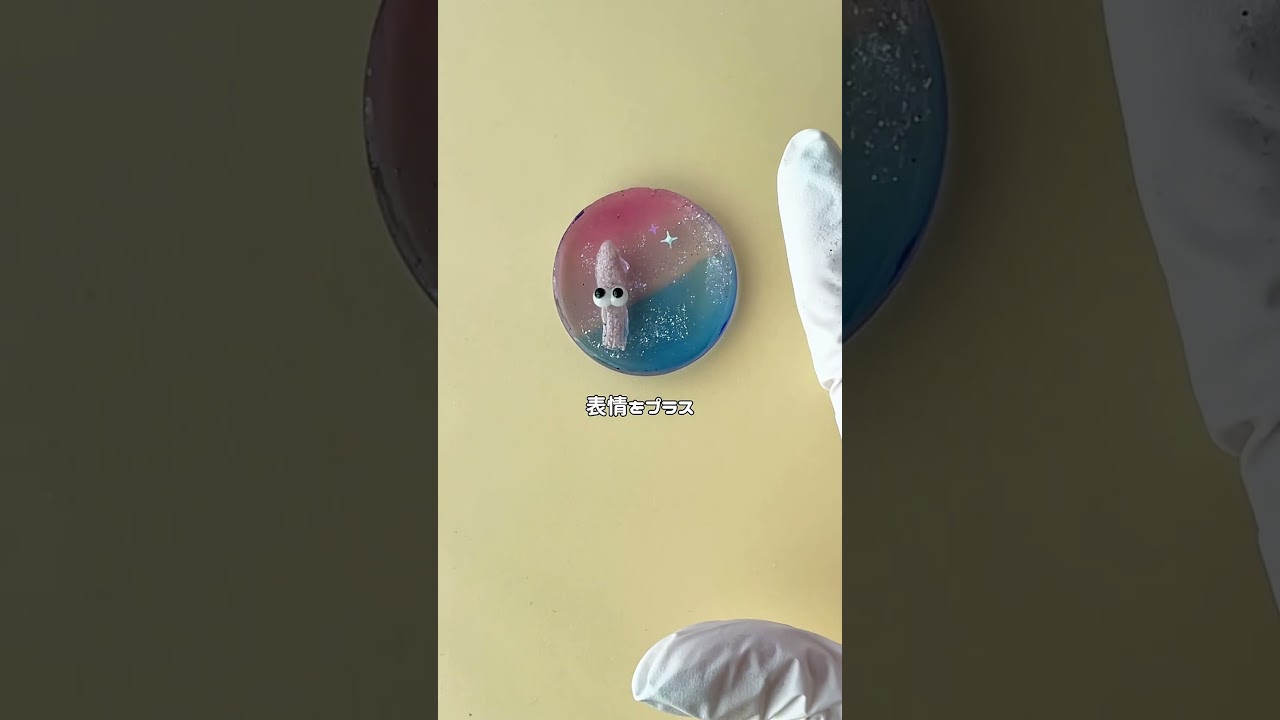

出典:YouTube / ハピネス⑅◡̈*レジン
100均DIY動画情報
| タイトル | 《レジンで喫茶店のメニュー作ってみた》 #ハンドメイド #レジン #100均diy #resin #shorts |
|---|---|
| 説明文 | こちらは、ミミちゃんのかわいい企画に参加させてもらってます@mimikiki2383 ちゃんメンションできとるかなミミちゃんいつもありがとう♡... |
| 公開日時 | 2025-06-18 17:06:38 |
| 長さ | 00:30 |
| 再生回数 | 10382 |
| チャンネル名 | ハピネス⑅◡̈*レジン |
| チャンネルURL | https://www.youtube.com/channel/UCyPkTAzdTpeUyWB9KUb0KfQ |
| 動画サムネイル |     |
| 動画URL | https://www.youtube.com/watch?v=RCSmrZQ8_Oc |

コメント